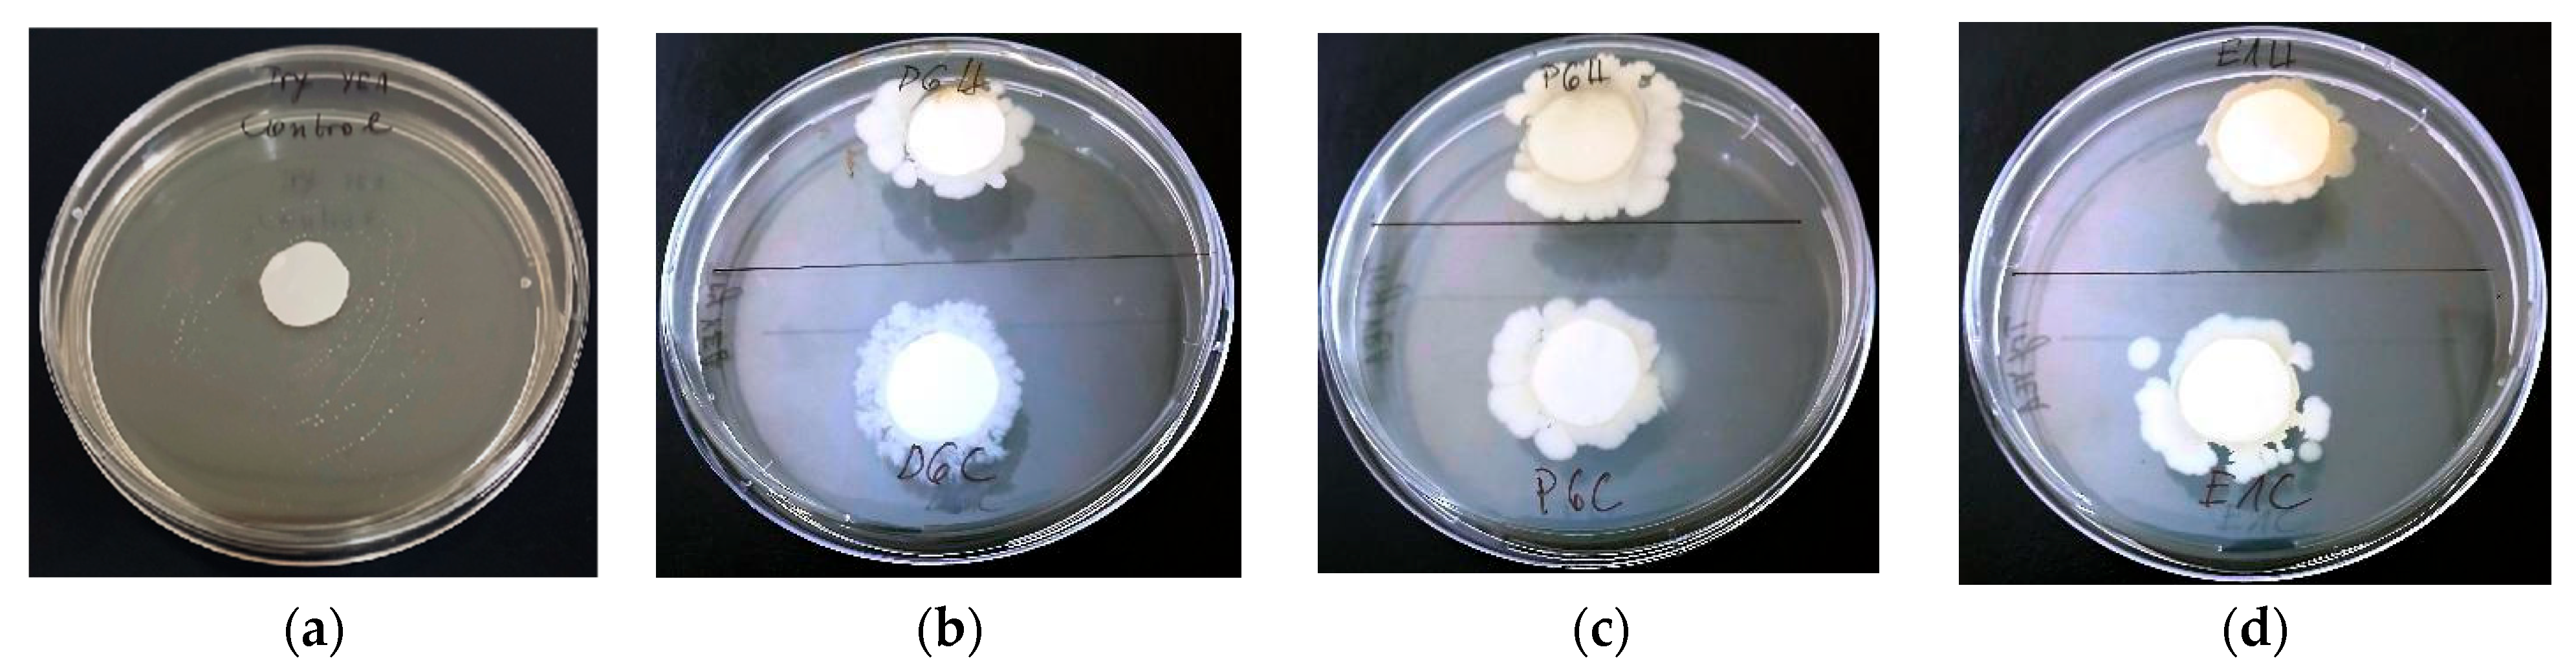
Agronomy 15 01541 g004
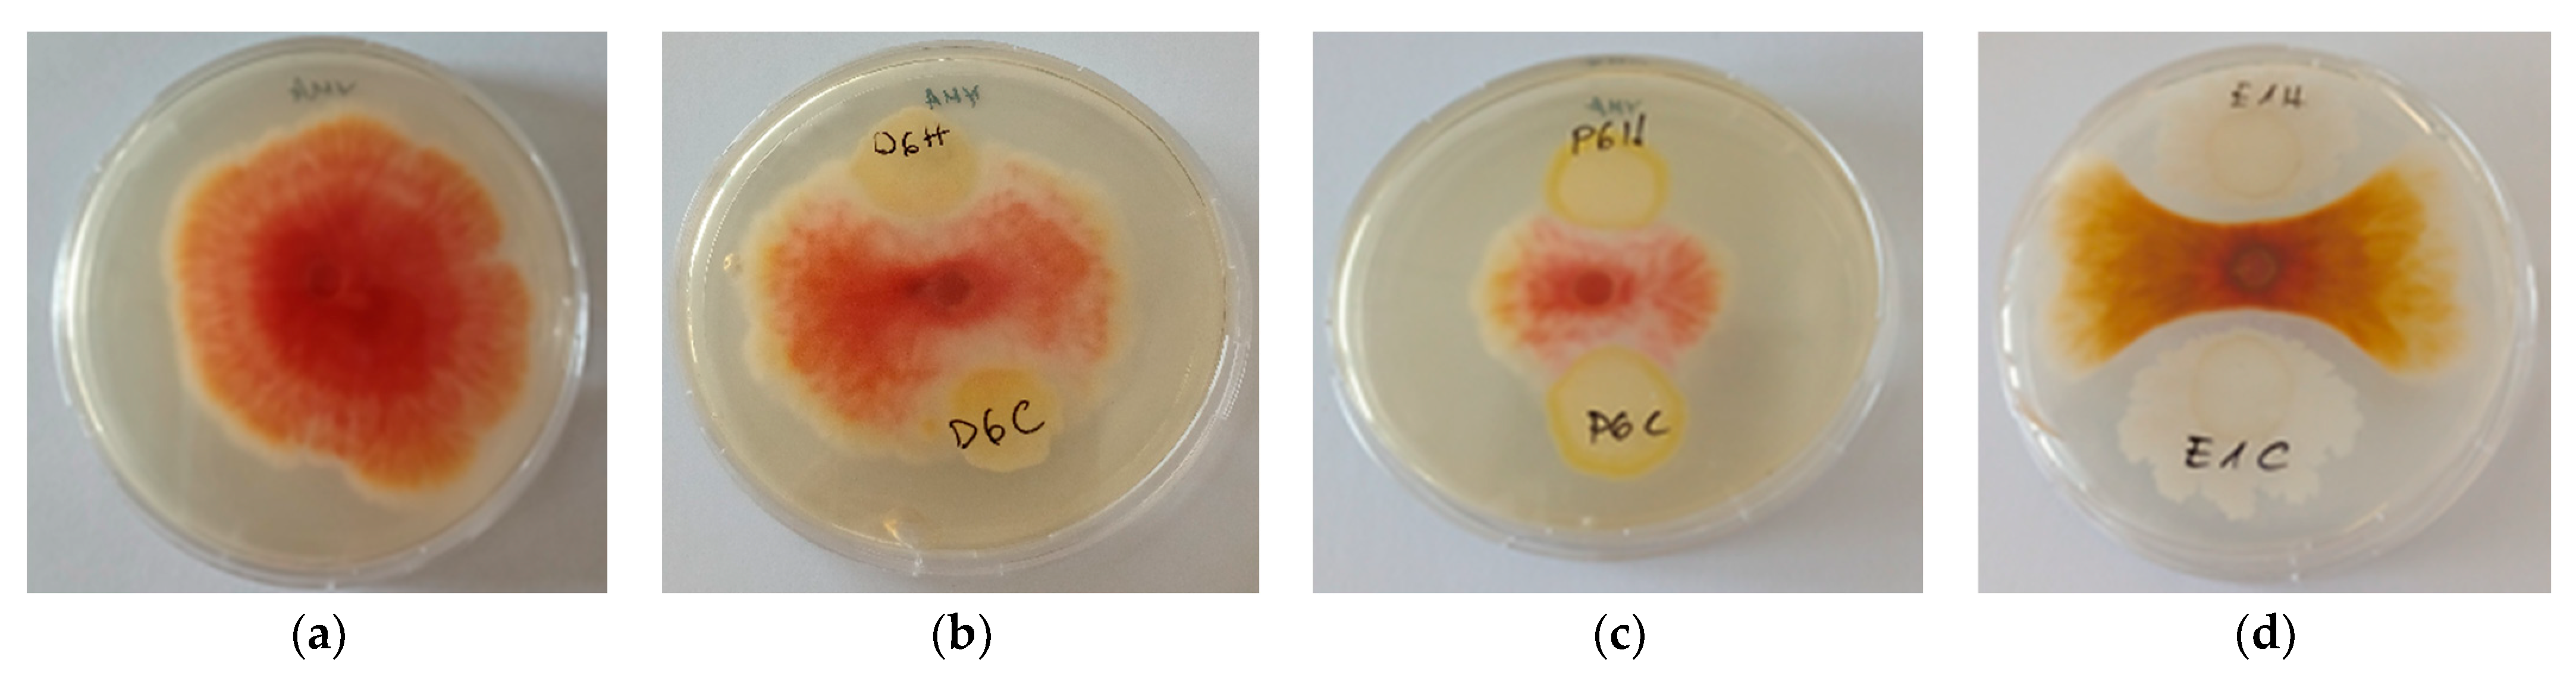
Agronomy 15 01541 g005

Electrospun Biocarriers with Immobilized Yeasts for Eco-Friendly Biocontrol of Fusarium graminearum
Abstract
1. Introduction
2. Materials and Methods
2.1. Materials
2.2. Preparation of Fibrous Materials
2.3. Fibrous Materials Characterization
2.4. Yeast and Fungal Pathogen Isolation, Identification, and Cultivation
2.5. Sporulation and Radial Growth of Immobilized Yeasts
2.6. Antifungal Activity Assessed by Double-Layer Agar Assay
2.7. Statistical Analysis
3. Results and Discussion
3.1. Morphological Analysis by SEM
3.2. Surface Wettability Analysis of Electrospun PHB Mats
3.3. Molecular Identification and Taxonomic Classification of Yeast Strains
3.4. Comparative Radial Growth of Immobilized Yeast Strains
3.5. Antifungal Activity of Immobilized Yeasts Against Fusarium Graminearum
4. Conclusions
Supplementary Materials
Author Contributions
Funding
Data Availability Statement
Acknowledgments
Conflicts of Interest
Abbreviations
| PHB | Poly(3-hydroxybutyrate) |
| COS | Chitosan oligosaccharide |
| HEC | 2-Hydroxyethyl cellulose |
| SEM | Scanning Electron Microscopy |
References
- Ristaino, J.B.; Anderson, P.K.; Bebber, D.P.; Brauman, K.A.; Cunniffe, N.J.; Fedoroff, N.V.; Finegold, C.; Garrett, K.A.; Gilligan, C.A.; Jones, C.M.; et al. The persistent threat of emerging plant disease pandemics to global food security. Proc. Natl. Acad. Sci. USA 2021, 118, e2022239118. [Google Scholar] [CrossRef]
- Rashad, Y.M.; Moussa, T.A.A. Biocontrol agents for fungal plant diseases management. In Cottage Industry of Biocontrol Agents and Their Applications; El-Wakeil, N., Saleh, M., Abu-hashim, M., Eds.; Springer International Publishing: Berlin/Heidelberg, Germany, 2020; pp. 337–363. [Google Scholar] [CrossRef]
- Motaung, T.E.; Saitoh, H.; Tsilo, T.J. Large-scale molecular genetic analysis in plant-pathogenic fungi: A decade of genome-wide functional analysis. Mol. Plant Pathol. 2017, 18, 754–764. [Google Scholar] [CrossRef] [PubMed]
- Benkeblia, N. Significance, management, and control. Chapter 13—Fungal diseases in agriculture. In Mycoagroecology; Gall, E., Benkeblia, N., Eds.; CRC Press: Boca Raton, FL, USA, 2022; pp. 161–174. [Google Scholar] [CrossRef]
- Burdon, J.J.; Thrall, P.H. Pathogen evolution across the agro-ecological interface: Implications for disease management. Evol. Appl. 2008, 1, 57–65. [Google Scholar] [CrossRef]
- Stukenbrock, E.H.; McDonald, B.A. The origins of plant pathogens in agro-ecosystems. Annu. Rev. Phytopathol. 2008, 46, 75–100. [Google Scholar] [CrossRef] [PubMed]
- Curl, C.L.; Spivak, M.; Phinney, R.; Montrose, L. Synthetic pesticides and health in vulnerable populations: Agricultural workers. Curr. Environ. Health Rep. 2020, 7, 13–29. [Google Scholar] [CrossRef] [PubMed]
- Ankit, S.L.; Kishor, V.; Bauddh, K. Impacts of synthetic pesticides on soil health and non-targeted flora and fauna. In Ecological and Practical Applications for Sustainable Agriculture; Springer: Berlin/Heidelberg, Germany, 2020; pp. 65–88. [Google Scholar] [CrossRef]
- Martínez-Burgos, W.J.; Pozzan, R.; da Silva Vale, A.; de Carvalho, J.C.; Iwamoto, H.; de Souza Vandenberghe, L.P.; Manzoki, M.C.; Scapini, T.; Severo, I.A.; Soccol, C.R. Bioremediation of microalgae-based pesticides. In Algae as a Natural Solution for Challenges in Water-Food-Energy Nexus: Toward Carbon Neutrality; Kurniawan, T.A., Anouzla, A., Eds.; Springer Nature: Singapore, 2024; pp. 903–929. [Google Scholar] [CrossRef]
- Compant, S.; Duffy, B.; Nowak, J.; Clément, C.; Barka, E.A. Use of plant growth-promoting bacteria for biocontrol of plant diseases: Principles, mechanisms of action, and future prospects. Appl. Environ. Microbiol. 2005, 71, 4951–4959. [Google Scholar] [CrossRef]
- Lugtenberg, B.; Kamilova, F. Plant-growth-promoting rhizobacteria. Annu. Rev. Microbiol. 2009, 63, 541–556. [Google Scholar] [CrossRef]
- Pieterse, C.M.; Zamioudis, C.; Berendsen, R.L.; Weller, D.M.; Van Wees, S.C.; Bakker, P.A. Induced systemic resistance by beneficial microbes. Annu. Rev. Phytopathol. 2014, 52, 347–375. [Google Scholar] [CrossRef]
- Wu, F.; Wang, H.; Lin, Y.; Feng, S.; Li, X. Biocontrol mechanisms of antagonistic yeasts on postharvest fruits and vegetables and the approaches to enhance the biocontrol potential of antagonistic yeasts. Int. J. Food Microbiol. 2025, 430, 1–10. [Google Scholar] [CrossRef]
- Petkova, M.; Petrova, S.; Spasova-Apostolova, V.; Naydenov, M. Tobacco plant growth-promoting and antifungal activities of three endophytic yeast strains. Plants 2022, 11, 751. [Google Scholar] [CrossRef]
- Petkova, M.; Petrova, S.; Spasova-Apostolova, V.; Naydenov, M.; Masheva, V. Biosynthetic and biocontrol potential of endophytic yeast strains YP6 And YBS14 for improvement the growth and development of Solanaceae plants. Sci. Pap. Ser. A Agron. 2023, LXVI, 508–518. [Google Scholar]
- Podgórska-Kryszczuk, I.; Solarska, E.; Kordowska-Wiater, M. Biological control of Fusarium culmorum, Fusarium graminearum and Fusarium poae by antagonistic yeasts. Pathogens 2022, 11, 86. [Google Scholar] [CrossRef]
- Shude, S.; Yobo, K.S.; Mbili, N.C. Progress in the management of Fusarium head blight of wheat: An overview. S. Afr. J. Sci. 2020, 116, 1–7. [Google Scholar] [CrossRef]
- Powell, A.J.; Vujanovic, V. Evolution of Fusarium head blight management in wheat: Scientific perspectives on biological control agents and crop genotypes protocooperation. Appl. Sci. 2021, 11, 8960. [Google Scholar] [CrossRef]
- Nachev, N.; Spasova, M.; Manolova, N.; Rashkov, I.; Naydenov, M. Electrospun polymer materials with fungicidal activity: A Review. Molecules 2022, 27, 5738. [Google Scholar] [CrossRef]
- Santos, M.S.M.; Batistote, M.; Cardoso, C.A.L. The production of metabolites by Saccharomyces cerevisiae and its application in biotechnological processes. Front. J. Soc. Technol. Environ. Sci. 2021, 10, 174–184. [Google Scholar] [CrossRef]
- Tan, C.; Wang, J.; Sun, B. Polysaccharide dual coating of yeast capsules for stabilization of anthocyanins. Food Chem. 2021, 357, 129652. [Google Scholar] [CrossRef]
- Canbolat, M.F.; Gera, N.; Tang, C.; Monian, B.; Rao, B.M.; Pourdeyhimi, B.; Khan, S.A. Preservation of cell viability and protein conformation on immobilization within nanofibers via electrospinning functionalized yeast. ACS Appl. Mater. Interfaces 2013, 5, 9349–9354. [Google Scholar] [CrossRef] [PubMed]
- Guo, Z.; Teng, W.; Xiao, H.; Zhang, Y.; Luo, Y.; Pang, J.; Ning, Q. Immobilization of Saccharomyces cerevisiae on polyhydroxyalkanoate/konjac glucan nanofiber membranes: Characterization, immobilization efficiency and cellular activity. Carbohydr. Polym. 2025, 352, 122606. [Google Scholar] [CrossRef]
- Seggiani, M.; Cinelli, P.; Verstichel, S.; Puccini, M.; Vitolo, S.; Anguillesi, I.; Lazzeri, A. Development of fibres-reinforced biodegradable composites. Chem. Eng. Trans. 2015, 43, 1813–1818. [Google Scholar] [CrossRef]
- Jaffur, N.B.; Jeetah, P.; Kumar, G. Harnessing the power of mauritius hemp fibres for polyhydroxybutyrate biopolymer synthesis. In Innovation, Social Responsibility and Sustainability; Emerald Publishing Limited: Leeds, UK, 2023; pp. 139–171. [Google Scholar] [CrossRef]
- Tsekova, P.; Nachev, N.; Valcheva, I.; Draganova, D.; Naydenov, M.; Spasova, M.; Stoilova, O. Encapsulation of Bacillus subtilis in electrospun poly(3-hydroxybutyrate) fibers coated with cellulose derivatives for sustainable agricultural applications. Polymers 2024, 16, 2749. [Google Scholar] [CrossRef]
- Krastev, V.; Stoyanova, N.; Valcheva, I.; Draganova, D.; Naydenov, M.; Spasova, M.; Stoilova, O. Development of chitosan-coated electrospun poly(3-hydroxybutyrate) biohybrid materials for growth and long-term storage of Bacillus subtilis. Polysaccharides 2024, 5, 698–714. [Google Scholar] [CrossRef]
- Yeo, J.; Muiruri, J.; Thitsartarn, W.; Li, Z.; He, C. Recent advances in the development of biodegradable PHB-based toughening materials: Approaches, advantages and applications. Mater. Sci. Eng. C 2018, 92, 1092–1116. [Google Scholar] [CrossRef]
- Petkova, M.; Marcheva, M.; Petrova, A.-L.; Slavova, V.; Shilev, S. Plant growth-promoting and biocontrol characteristics of four Bacillus strains and evaluation of their effects on wheat (Tr. aestivum L.). Int. J. Plant Biol. 2025, 16, 1. [Google Scholar] [CrossRef]
- Meneghin, M.C.; Reis, V.R.; Ceccato-Antonini, S.R. Inhibition of bacteria contaminating alcoholic fermentations by killer yeasts. Braz. Arch. Biol. Technol. 2010, 53, 1043–1050. [Google Scholar] [CrossRef]
- R Core Team. R: A Language and Environment for Statistical Computing; R Foundation for Statistical Computing: Vienna, Austria, 2023; Available online: https://www.R-project.org/ (accessed on 3 March 2025).
- Van der Walt, J.P. Pichia acaciae sp. n. Antonie van Leeuwenhoek 1966, 32, 159–161. [Google Scholar] [CrossRef]
- Zakhartsev, M.; Reuss, M. Cell size and morphological properties of yeast Saccharomyces cerevisiae in relation to growth temperature. FEMS Yeast Res. 2018, 18, foy052. [Google Scholar] [CrossRef]
- Jasme, N.; Elangovan, J.; Mohd Yahya, A.R.; Md Noh, N.A.; Bustami, Y. First report of biocellulose production by an indigenous yeast, Pichia kudriavzevii USM-YBP2. Green Process. Synth. 2022, 11, 458–477. [Google Scholar] [CrossRef]
- Shrivastava, A.; Pal, M.; Sharma, R.K. Pichia as yeast cell factory for production of industrially important bio-products: Current trends, challenges, and future prospects. J. Bioresour. Bioprod. 2023, 8, 108–124. [Google Scholar] [CrossRef]
- Suzzi, G.; Romano, P.; Benevelli, M. The flocculation of wine yeasts: Biochemical and morphological characteristics inZygosaccharomyces—Flocculation in Zygosaccharomyces. Antonie van Leeuwenhoek 1992, 61, 317–322. [Google Scholar] [CrossRef] [PubMed]
- Bai, Y.; Jing, Z.; Ma, R.; Wan, X.; Liu, J.; Huang, W. A critical review of enzymes immobilized on chitosan composites: Characterization and applications. Bioprocess Biosyst. Eng. 2023, 46, 1539–1567. [Google Scholar] [CrossRef]
- Żywicka, A.; Wenelska, K.; Junka, A.; Chodaczek, G.; Szymczyk, P.; Fijałkowski, K. Immobilization pattern of morphologically different microorganisms on bacterial cellulose membranes. World J. Microbiol. Biotechnol. 2019, 35, 1–11. [Google Scholar] [CrossRef]
- Spasova, M.; Stoilova, O.; Manolova, N.; Rashkov, I.; Naydenov, M. Electrospun eco-friendly materials based on poly(3-hydroxybutyrate) (PHB) and TiO2 with antifungal activity prospective for Esca treatment. Polymers 2020, 12, 1384. [Google Scholar] [CrossRef]
- Badawy, M.E.; Rabea, E.I. A biopolymer chitosan and its derivatives as promising antimicrobial agents against plant pathogens and their applications in crop protection. Int. J. Carbohydr. Chem. 2011, 460381, 1–29. [Google Scholar] [CrossRef]
- Liu, H.; Du, Y.; Wang, X.; Sun, L. Chitosan kills bacteria through cell membrane damage. Int. J. Food Microbiol. 2004, 95, 147–155. [Google Scholar] [CrossRef]
- Buzzini, P.; Lachance, M.A.; Yurkov, A. (Eds.) Yeasts in Natural Ecosystems: Diversity; Springer International Publishing: Basel, Switzerland, 2017; Volume 499. [Google Scholar]
- Zhang, X.; Li, B.; Zhang, Z.; Chen, Y.; Tian, S. Antagonistic yeasts: A promising alternative to chemical fungicides for controlling postharvest decay of fruit. J. Fungi 2020, 6, 158. [Google Scholar] [CrossRef]
- Sharp, R.G. A Review of the applications of chitin and its derivatives in agriculture to modify plant-microbial interactions and improve crop yields. Agronomy 2013, 3, 757–793. [Google Scholar] [CrossRef]
- Verma, R.K.; Bohra, Y.; Gautam, A.K.; Avasthi, S.; Ashok, D. Role of microbial biofilms in bioremediation: Current perspectives. Microb. Inoculants 2023, 253–276. [Google Scholar] [CrossRef]
- Fleet, G.H. Yeast interactions and wine flavour. Int. J. Food Microbiol. 2003, 86, 11–22. [Google Scholar] [CrossRef]
- Spadaro, D.; Droby, S. Development of biocontrol products for postharvest diseases of fruit: The importance of elucidating the mechanisms of action of yeast antagonists. Trends Food Sci. Technol. 2016, 47, 39–49. [Google Scholar] [CrossRef]
- El-Tarabily, K.A.; Sivasithamparam, K. Potential of yeasts as biocontrol agents of soil-borne fungal plant pathogens and as plant growth promoters. Mycoscience 2006, 47, 25–35. [Google Scholar] [CrossRef]
- Droby, S.; Wisniewski, M.; Macarisin, D.; Wilson, C. Twenty years of postharvest biocontrol research: Is it time for a new paradigm? Postharvest Biol. Technol. 2009, 52, 137–145. [Google Scholar] [CrossRef]
- Westphal, K.R.; Wollenberg, R.D.; Herbst, F.-A.; Sørensen, J.L.; Sondergaard, T.E.; Wimmer, R. Enhancing the production of the fungal pigment aurofusarin in Fusarium graminearum. Toxins 2018, 10, 485. [Google Scholar] [CrossRef]
- Jarolim, K.; Wolters, K.; Woelflingseder, L.; Pahlke, G.; Beisl, J.; Puntscher, H.; Braun, D.; Sulyok, M.; Warth, B.; Marko, D. The secondary Fusarium metabolite aurofusarin induces oxidative stress, cytotoxicity and genotoxicity in human colon cells. Toxicol. Lett. 2018, 284, 170–183. [Google Scholar] [CrossRef]
- Moure, C.; Albuquerque, D.R.; Peláez, A.L.; Pinto, V.F.; Alconada, T. Impact of kefir yeasts on Fusarium graminearum growth and production of deoxynivalenol. Int. Microbiol. 2025. Online ahead of print. [Google Scholar] [CrossRef]
- Papp, L.A.; Horváth, E.; Peles, F.; Pócsi, I.; Miklós, I. Insight into yeast–mycotoxin relations. Agriculture 2021, 11, 1291. [Google Scholar] [CrossRef]
- Kolawole, O.; Meneely, J.; Petchkongkaew, A.; Elliott, C. A review of mycotoxin biosynthetic pathways: Associated genes and their expressions under the influence of climatic factors. Fungal Biol. Rev. 2021, 37, 8–26. [Google Scholar] [CrossRef]
- Weiler, F.; Schmitt, M.J. Zygocin, a secreted antifungal toxin of the yeast Zygosaccharomyces bailii, and its effect on sensitive fungal cells. FEMS Yeast Res. 2003, 3, 69–76. [Google Scholar] [CrossRef]
- Schmitt, M.; Breinig, F. Yeast viral killer toxins: Lethality and self-protection. Nat. Rev. Microbiol. 2006, 4, 212–221. [Google Scholar] [CrossRef]
- Belda, I.; Ruiz, J.; Alonso, A.; Marquina, D.; Santos, A. The Biology of Pichia membranifaciens Killer Toxins. Toxins 2017, 9, 112. [Google Scholar] [CrossRef]
- İzgü, F.; Altınbay, D.; Acun, T. Killer toxin of Pichia anomala NCYC 432; purification, characterization and its exo-β-1, 3-glucanase activity. Enzyme Microb. Technol. 2006, 39, 669–676. [Google Scholar] [CrossRef]
- de Oliveira, A.J.; Ono, M.A.; Suguiura, I.M.D.S.; Zucareli, C.; Garcia, E.B.; Olchanheski, L.R.; Ono, E.Y.S. Potential of yeasts as biocontrol agents against Fusarium graminearum in vitro and on corn. J. Appl. Microbiol. 2023, 134, lxad296. [Google Scholar] [CrossRef]
- Walker, G.M. Pichia anomala: Cell physiology and biotechnology relative to other yeasts. Antonie van Leeuwenhoek 2011, 99, 25–34. [Google Scholar] [CrossRef]
- Benchamas, G.; Huang, G.; Huang, S.; Huang, H. Preparation and biological activities of chitosan oligosaccharides. Trends Food Sci. Technol. 2021, 107, 38–44. [Google Scholar] [CrossRef]
- Loron, A.; Wang, Y.; Atanasova, V.; Richard-Forget, F.; Gardrat, C.; Coma, V. Chitosan for eco-friendly control of mycotoxinogenic Fusarium graminearum. Food Hydrocoll. 2023, 134, 108067. [Google Scholar] [CrossRef]
- Rabea, E.I.; Badawy, M.E.T.; Stevens, C.V.; Smagghe, G.; Steurbaut, W. Chitosan as antimicrobial agent: Applications and mode of action. Biomacromolecules 2003, 4, 1457–1465. [Google Scholar] [CrossRef]
- Riley, R.; Haridas, S.; Wolfe, K.H.; Lopes, M.R.; Hittinger, C.T.; Göker, M.; Salamov, A.A.; Wisecaver, J.H.; Long, T.M.; Calvey, C.H.; et al. Comparative genomics of biotechnologically important yeasts. Proc. Natl. Acad. Sci. USA 2016, 113, 9882–9887. [Google Scholar] [CrossRef]
- Selitrennikoff, C.P. Antifungal proteins. Appl. Environ. Microbiol. 2001, 67, 2883–2894. [Google Scholar] [CrossRef]

| Strain Name | Identification | % Similarity | GenBank Accession Number |
|---|---|---|---|
| YD6 1 | P. acaiae 1 | 99 | MW756319 |
| YP6 2 | P. fermentans 2 | 100 | MZ798453.1 |
| YE1 3 | Z. bailii 3 | 100 | OL904963 |
| Biocarrier | Strain | Colony Diameter, mm |
|---|---|---|
| PHB/COS/YD6 | P. acaciae YD6 | 18.50 ± 1.95 b |
| PHB/HEC/YD6 | P. acaciae YD6 | 15.23 ± 1.08 c |
| PHB/COS/YP6 | P. fermentans YP6 | 19.05 ± 1.88 b |
| PHB/HEC/YP6 | P. fermentans YP6 | 16.45 ± 2.14 b,c |
| PHB/COS/YE1 | Z. bailii YE1 | 18.03 ± 0.92 a |
| PHB/HEC/YE1 | Z. bailii YE1 | 15.30± 1.99 a |
Disclaimer/Publisher’s Note: The statements, opinions and data contained in all publications are solely those of the individual author(s) and contributor(s) and not of MDPI and/or the editor(s). MDPI and/or the editor(s) disclaim responsibility for any injury to people or property resulting from any ideas, methods, instructions or products referred to in the content. |
© 2025 by the authors. Licensee MDPI, Basel, Switzerland. This article is an open access article distributed under the terms and conditions of the Creative Commons Attribution (CC BY) license (https://creativecommons.org/licenses/by/4.0/).
Share and Cite
Tsekova, P.; Petkova, M.; Spasova, M.; Stoilova, O. Electrospun Biocarriers with Immobilized Yeasts for Eco-Friendly Biocontrol of Fusarium graminearum. Agronomy 2025, 15, 1541. https://doi.org/10.3390/agronomy15071541
Tsekova P, Petkova M, Spasova M, Stoilova O. Electrospun Biocarriers with Immobilized Yeasts for Eco-Friendly Biocontrol of Fusarium graminearum. Agronomy. 2025; 15(7):1541. https://doi.org/10.3390/agronomy15071541
Chicago/Turabian StyleTsekova, Petya, Mariana Petkova, Mariya Spasova, and Olya Stoilova. 2025. "Electrospun Biocarriers with Immobilized Yeasts for Eco-Friendly Biocontrol of Fusarium graminearum" Agronomy 15, no. 7: 1541. https://doi.org/10.3390/agronomy15071541
APA StyleTsekova, P., Petkova, M., Spasova, M., & Stoilova, O. (2025). Electrospun Biocarriers with Immobilized Yeasts for Eco-Friendly Biocontrol of Fusarium graminearum. Agronomy, 15(7), 1541. https://doi.org/10.3390/agronomy15071541

